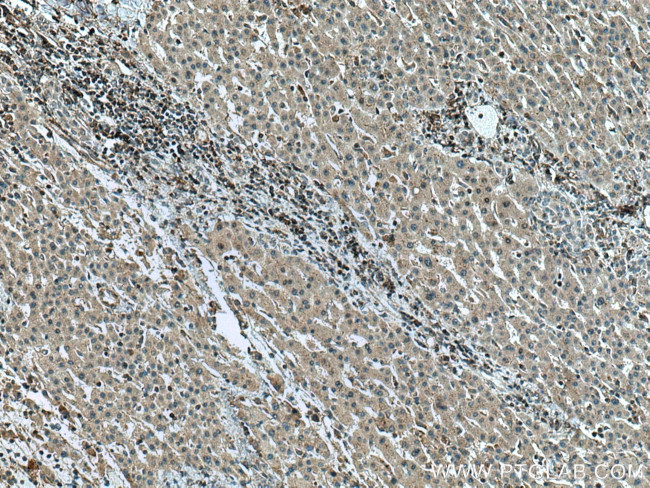
GCK Antibody in Immunohistochemistry (Paraffin) (IHC (P))

Search
Proteintech
GCK Polyclonal Antibody
{{$productOrderCtrl.translations['antibody.pdp.commerceCard.promotion.promotions']}}
{{$productOrderCtrl.translations['antibody.pdp.commerceCard.promotion.viewpromo']}}
{{$productOrderCtrl.translations['antibody.pdp.commerceCard.promotion.promocode']}}: {{promo.promoCode}} {{promo.promoTitle}} {{promo.promoDescription}}. {{$productOrderCtrl.translations['antibody.pdp.commerceCard.promotion.learnmore']}}
产品信息
15629-1-AP
种属反应
宿主/亚型
分类
类型
抗原
偶联物
形式
浓度
规格
纯化类型
保存液
内含物
保存条件
运输条件
产品详细信息
Immunogen sequence: EDIDKGILL NWTKGFKASG AEGNNVVGLL RDAIKRRGDF EMDVVAMVND TVATMISCYY EDHQCEVGMI VGTGCNACYM EEMQNVELVE GDEGRMCVNT EWGAFGDSGE LDEFLLEYDR LVDESSANPG QQLYEKLIGG KYMGELVRLV LLRLVDENLL FHGEASEQLR TRGAFETRFV SQVESDTGDR KQIYNILSTL GLRPSTTDCD IVRRACESVS TRAAHMCSAG LAGVINRMRE SRSEDVMRIT VGVDGSVYKL HPSFKERFHA SVRRLTPSCE ITFIESEEGS GRGAALVSAV ACKKACMLGQ (157-465 aa encoded by BC001890)
靶标信息
Hexokinases phosphorylate glucose to produce glucose-6-phosphate, thus committing glucose to the glycolytic pathway. Alternative splicing of this gene results in three tissue-specific forms of glucokinase, one found in pancreatic islet beta cells and two found in liver. The protein localizes to the outer membrane of mitochondria. In contrast to other forms of hexokinase, this enzyme is not inhibited by its product glucose-6-phosphate but remains active while glucose is abundant. Mutations in this gene have been associated with non-insulin dependent diabetes mellitus (NIDDM), maturity onset diabetes of the young, type 2 (MODY2) and persistent hyperinsulinemic hypoglycemia of infancy (PHHI).
仅用于科研。不用于诊断过程。未经明确授权不得转售。
生物信息学
蛋白别名: ATP:D-hexose 6-phosphotransferase; GC kinase; Glucokinase; glucokinase (hexokinase 4); glucokinase variant 3; hexokinase 4; hexokinase D, pancreatic isozyme; Hexokinase type IV; Hexokinase-4; Hexokinase-D; HK IV; HK4; MEKKK 2; unnamed protein product
基因别名: FGQTL3; GCK; GK; GLK; Gls006; GLUKA; HHF3; HK4; HKIV; Hlb62; HXKP; LGLK; MODY2; PNDM1; RNGK2
UniProt ID: (Human) P35557, (Rat) P17712, (Mouse) P52792
Entrez Gene ID: (Human) 2645, (Rat) 24385, (Mouse) 103988